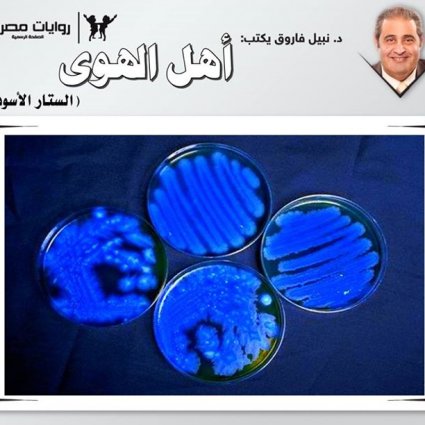

1412 مشاهدة
0
0
أنا الوحش الجبار .. " نطقها الطفل الصغير، ذو الأعوام الستة، وهو يعقد حاجبيه في شدة، ويبرز أنيابه الصغيرة على نحو مضحك، جعل والدته تبتسم، إلى أن تبين قصده
"أنا الوحش الجبار .. "نطقها الطفل الصغير، ذو الأعوام الستة، وهو يعقد حاجبيه في شدة، ويبرز أنيابه الصغيرة على نحو مضحك، جعل والدته تبتسم، وهي تقول:
ـ لقد أخفتني بالفعل.
ضحك الصغير في مرح، وانطلق عائدًا إلى حجرته، وهو يصرخ:
ـ أنا المرعب.
عقد الوالد حاجبيه في قلق، وهو يقول:
ـ إنهم يفسدون عقول الصغار بتلك الخرافات، التي تزخر بها الأفلام السينمائية هذه الأيام.
ابتسمت الوالدة في حنان، وهي تقول:
ـ ابنك يتميز بخيال جامح.
غمغم في ضيق:
ـ وعدواني .
اقتربت منها الخادمة، وقطعت حديثهما، وهي تقول في آلية:
ـ هل ننظف حجرة السيد الكبير اليوم؟
التفتت الزوجة إلى زوجها في قلق، وقالت:
ـ ما رأيك؟
مط شفتيه، وتنهد قائلًا:
ـ لا بأس .. إنها لن تبقى مغلقة للأبد.
بدا الارتياح على وجه الخادمة، وانصرفت إلى حيث حجرة الجد، الذي انتقل إلى رحمة الله منذ عام كامل، وراقبتها الوالدة، وهي تختفي في نهاية الممر الطويل، الذي يقود إلى الحجرة، ثم ربتت على كتف زوجها، قائلة في إشفاق:
ـ يسعدني أنك قد وافقت أخيرًا.
أشاح بوجهه، ليخفي دمعة ترقرقت في عينيه، وهو يقول:
ـ أنتِ تعلمين كم كنت أحب أبي، حتى أنني أعجز عن رؤية حجرته خالية !
ربتت على كفه مرة أخرى، وقالت في حنان:
ـ ولكن كان من الضروري أن ننظف الحجرة، فهي لن تبقى أكثر من عام مغلقة.
تمتم وهو يمسح دمعته خفية:
ـ بالتأكيد.
اندفع الصغير إلى حيث يجلسان، وهتف في حماس:
ـ أمي .. أبي .. لقد عثرت الخادمة على حفرة عميقة في حجرة جدي.
داعب الوالد رأس الصغير، وغمغم:
ـ لا باس يا صغيري .. لا بأس.
ابتسم الصغير في مرح، ولوح بكفيه، قائلًا:
ـ هل سيخرج منها الوحش الكبير؟
ربت على رأسه ، قائلًا:
لا توجد وحوش كبيرة أو صغيرة، في عالم الواقع يا بني .. كل هذا مجرد خيال.
أومأ الصغير برأسه متفهمًا، وأسرع إلى حجرة الجد/ ووالدته تهتف به:
ـ حذارٍ من الأتربة الكثيفة:
والتفتت إلى زوجها، مستطردة:
ـ ألم أقل لك إنه يمتلك خيالًا جامحًا؟
تمتم الوالد:
ـ أكثر مما ينبغي.
اندفع الصغير مغادرًا حجرة الجد، وهو يهتف:
ـ أبي ... أمي .. لقد صعد الوحش الكبير من الحجرة، وأمسك الخادمة.
عقد والده حاجبيه، وهو يقول في صرامة:
ـ ينبغي أن تكف عن هذا اللغو.
قالت الوالدة، محاولة تهدئة الأب:
ـ إنه مجرد كلام طفل، و...
قاطعها في حدة:
ـ بل هو كذب متعمد.
خشيت أن يتعاظم الأمر، فقالت:
ـ صدقني .. إنه كلام أطفال.
أما الصغير، فقد شحب وجهه، وغمغم:
ـ لقد خرج الوحش من الحفرة بالفعل، وأمسك الخادمة، وجذبها إلى حفرته ليلتهمها.
قال والده في صرامة:
ـ هكذا؟! .. لماذا إذن لم تصرخ الخادمة مستنجدة؟
لوح الصغير بذراعيه، هاتفًا:
ـ لقد أمسك وجهها، وكتم فمها، و ...
صرخ به والده:
ـ كف عن هذا.
ثم جذبه من ذراعه، واتجه نحو حجرة الجد، مستطردًا:
ـ سأثبت لك أنك كاذب.
لحقت به الوالدة، وقد أدهشها أن يتجه زوجها إلى حجرة والده الراحل، التي خشي رؤيتها طيلة عام كامل، وهي تهتف:
ـ صدقني .. إنه مجرد كلام أطفال .. لا تجعله يثير أعصابك إلى هذا الحد.
رأت زوجها يحدق داخل حجرة الجد، ثم يتراجع في حدة، وأدركت أنه لم يحتمل رؤية الحجرة الخالية، كما كانت تتوقع، فلحقت به، وهي تقول مشفقة:
ـ أرأيت ما فعله بك كلام الأطفال .. لقد ..
بترت عبارتها بغتة، وأطلقت شهقة رعب قوية ..
لقد كانت هناك حفرة كبيرة في زاوية الغرفة، وإلى جوارها آثار مخالب حادة في الأرضية ..
وقد اختفت الخادمة المسكينة ..
اختفت إلى الأبد ..
________
(د. نبيل فاروق ـ كوكتيل 2000 ـ العدد رقم 8 ـ تحقيق)
نشر في 06 آذار 2017

تابع
متابع
تابع
متابع
تابع
متابع
تابع
متابع
تابع
متابع
تابع
متابع

 أديان
أديان علوم
علوم منوع
منوع ثقافة
ثقافة أدبيات
أدبيات تاريخ وجغرافيا
تاريخ وجغرافيا تقني
تقني